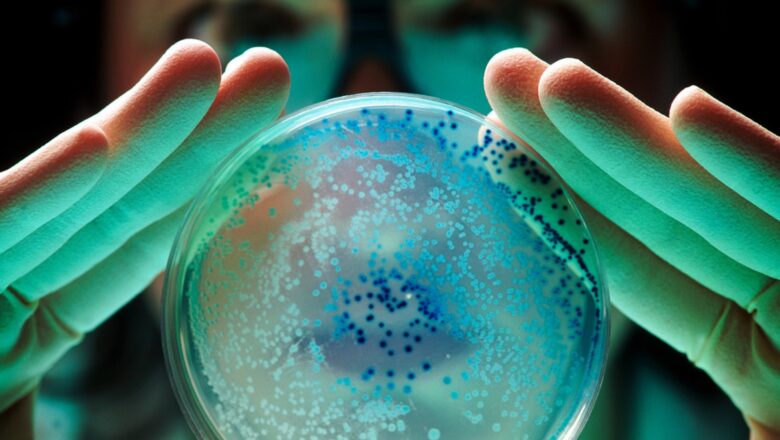

EXPORTACIÓN DE PALTAS AUMENTÓ 16% A JUNIO
Avance sostenido. Los despachos de palta, en sus diferentes presentaciones, sumaron 917 millones 349,000 dólares entre enero y junio de este año, lo cual implicó un crecimiento de 16% en comparación con lo registrado en igual período del 2024, destacó la Asociación de Exportadores (Adex).
Precisó que este resultado se explicó en la mayor demanda de Países Bajos. Al ser la puerta de entrada a Europa de un número importante de bienes nacionales, este destino (308 millones de dólares) concentró el 33.5% del total de envíos de esta fruta e incrementó sus pedidos en 18%.
Más mercados
En segundo lugar se ubicó España (154 millones de dólares), a pesar de disminuir su demanda en 3.3%; y luego Estados Unidos (134 millones de dólares), con un aumento de 42.4%. Ambos mercados acumularon el ...